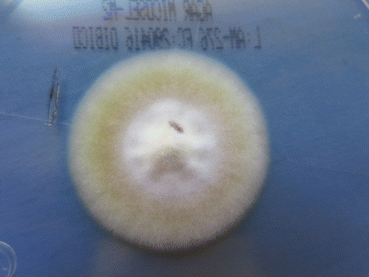
A417039_1_En_10_Fig5_HTML.gif

Fig. 10.1
Direct examination in nail clipping (chlorazol black 40×)
Long or septate filaments and arthrospores are observed under the microscope. In dermatophytic infection, a dermatophytoma can be found, this is a large accumulation of filaments and spores, and these fungal elements can explain in some cases the lack of response to treatment (Fig. 10.2).


Fig. 10.2
Dermatophytoma (chlorazol black 40x)
In Candida onychomycosis, one can visualize hyphae, pseudohyphae, and blastospores. In dematiaceous fungi we can find dark hyphae, but some non-dermatophytic molds may give similar images to dermatophytes, but in some of them, special characteristics are observed as, in Aspergillus, aspergillar heads; in Scopulariopsis, huge lemon-shaped spore; and, in Scytalidium, narrow and tortuous hyphae [4].
False negatives are due to inexperience in obtaining or reading the sample (20%). Microscopic exam does not allow us to distinguish the viable and nonviable forms [4].
Culture is performed in Sabouraud dextrose agar (SDA) with antibiotics such as chloramphenicol and cycloheximide (Actidione®) if a primary pathogenic fungus is suspected, but the use of culture mediums is convenient without Acti-dione® if one suspects a non-dermatophytic mold or a yeast (Figs. 10.3 and 10.4). It is convenient to put in the tube or in the Petri dish small fragments of the nail or to pulverize the sample [4].



Fig. 10.3
Candida spp. culture in SDA

Fig. 10.4
Candida spp. blastospores, hyphae, and pseudohyphae
Usually, it is difficult to isolate the causal agent given the poor sample and the low viability (30–60%); this percentage of false negatives increases after having received a recent treatment or when the scraping is not taken in the limit between the healthy and diseased nail.
Cultures must be incubated at room temperature (24–28° C), and the colonies can be observed from 1 week to 1 month, but NDM and yeasts can grow in less than 1 week; culture is considered negative after 3–6 weeks. If negative, it could be convenient to repeat the complete mycological study [1–4], especially if we have also a negative KOH.
Isolated fungi require a proper interpretation of the mycological samples, because not all the yeasts and non-dermatophytic molds are necessarily pathogens, and should be isolated in several occasions or should grow in abundance in the cultures.
If a specialized personnel is not available, DTM (dermatophyte test medium) is recommended; this is a medium with antibacterial and red phenol as indicators, so bacteria will be inhibited, and if a dermatophyte grows, there is a color virage from yellow to red.
The fungi more frequently isolated among dermatophytes are mainly Trichophyton rubrum (Fig. 10.5) and T. mentagrophytes var. interdigitale and very rare are T. mentagrophytes var. mentagrophytes, T. tonsurans, Epidermophyton floccosum, Microsporum canis, M. gypseum, T. soudanense, T. violaceum, T. erinacei, and T. equinum. Among the yeasts especially C. albicans and C. parapsilosis, some cases related with Candida ciferri and in immunocompromised hosts Candida glabrata. Among NDM: Scopulariopsis brevicaulis (Fig. 10.6), Fusarium sp. and Aspergillus sp., Acremonium sp., Paecilomyces sp., Onychocola canadensis Also Neoscytalidium sp., Alternaria alternata, Chaetomium globosum and another black fungi. It has been informed of lethal dissemination of the infection by Fusarium from an onychomycosis in a neutropenic patient [4].